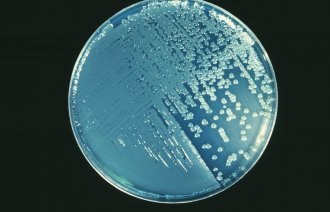
Bildet viser en petriskål med Pseudomonas aeruginosa.

Pseudomonas aeruginosa vurdert som sterkt medvirkende årsak til 8 dødsfall

– At kosmetiske produkter brukt på sårbare pasienter fører til sykdom og død, er kjempealvorlig, sier overlege Bjørn Iversen i FHI.
388 pasienter er smittet i det som Folkehelseinstituttet (FHI) mener er det største dokumenterte utbruddet i sykehus både nasjonalt og internasjonalt.
Blant de 388 tilfellene er det rapportert 56 dødsfall. Foreløpige rapporter viser at infeksjon med Pseudomonas er vurdert som sterkt medvirkende til død i 8 av dødsfallene. Det kommer frem i en ny rapport fra FHI.
Her kommer det også frem at Norsk pasientskadeerstatning har fått seks klagesaker i forbindelse med utbruddet. I to av disse sakene er smitten det eneste forholdet som er påklaget. I de fire andre er smitten ett av flere forhold, og ser ut til å ha mindre betydning.
– Kunne gått under radaren
Bakterien er påvist i en type engangs vaskekluter fra produsenten Vernacare i England. Disse ble trukket fra markedet i mars.
Siden smittekilden er fjernet og med det en nedgang i antall smittetilfeller, anser FHI utbruddet som over. Men de ser med stort alvor på at det inntraff.
– At kosmetiske produkter som er brukt på sårbare pasienter fører til sykdom og død, er kjempealvorlig, sier overlege Bjørn Iversen i FHI.
Han sier også at utbruddet kunne gått under radaren i lang tid, hvis det ikke hadde vært for en oppmerksom infeksjonslege ved Universitetssykehuset i Tromsø.
Hun reagerte på at tre inneliggende pasienter på intensiv alle fikk sepsis som var forårsaket av Pseudomonas aeruginosa. Ved helgenomsekvensering ble det avdekket at bakterien hos alle tre var av samme stamme. Denne stammen var ikke beskrevet tidligere.
Det ble satt i gang en omfattende etterforskning.
I mars fant overlege Egil Lingaas på Oslo universitetssykehus bakteriestammen i vaskeklutene. Disse klutene var i bruk i helsevesenet over hele landet.
Utbruddet omfatter 40 sykehus. Ifølge FHI kan det også komme flere tilfeller, fordi sykdom kan oppstå flere måneder etter at man er smittet.

– Må gå gjennom prosedyrer
Bjørn Iversen sier det nå er viktig å gå gjennom prosedyrer og anbefalinger for hva slags utstyr som skal brukes til de mest sårbare pasientene.
Klutene som var årsak til utbruddet er et ikke-sterilt kosmetisk produkt, og ikke pålagt å følge standard for medisinsk utstyr og legemidler. Men det skal likevel ikke være bakterier av typen Pseudomonas i slike produkter.
Talsperson for produsenten, Rachel Downham, har tidligere overfor Sykepleien understreket at deres produkter må gjennom robuste testprosedyrer, i tråd med internasjonale standarder, før de frigis.
Ifølge Bjørn Iversen i FHI er det et arbeid å gjøre knyttet til oppklaringen av et slikt utbrudd.
– En viktig lærdom av dette, er at vi ikke har laboratorier som er akkreditert for å teste blant annet utstyr for bakterier.
Dette er noe FHI mener nå må på plass.

0 Kommentarer